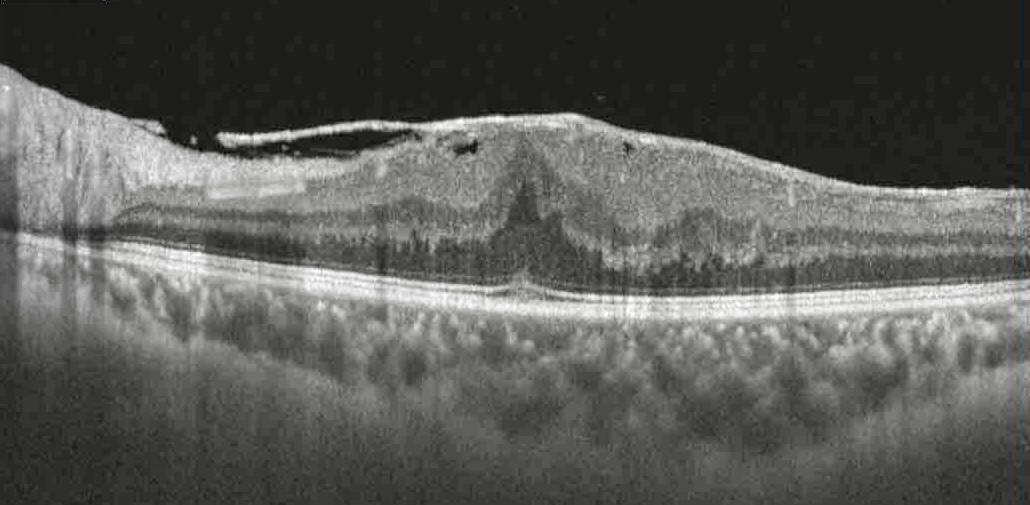
OCT Membrana Epirretiniana

Dr. Rodrigo Magno da Silva Oliveira
CRM 69770-MG | RQE 50784
Oftalmologista especialista em retina cirúrgica com 10 anos de experiência dedicados
ao cuidado da visão. Formado pela Universidade Federal de Ouro Preto, com residência
em oftalmologia e fellowship em retina e catarata pela UFMG.
Minha abordagem combina técnica avançada com atendimento humanizado, sempre priorizando
o bem-estar e a tranquilidade dos pacientes. Utilizo tecnologia OCT Zeiss de última
geração para diagnósticos precisos e tratamentos eficazes.
Formação e Qualificações
- Graduação: Universidade Federal de Ouro Preto
- Residência em Oftalmologia: UFMG
- Fellowship em Retina e Catarata: UFMG
- Especialização em Retina Cirúrgica
Falar com o Doutor